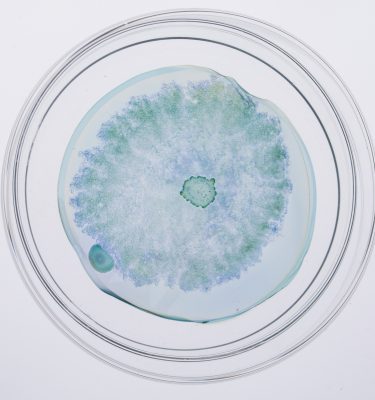

Parallèlement aux collections signées par les commissaires invités, ArtJaws propose également des sélections thématiques mettant en valeur certains courants de l’art contemporain et des nouveaux médias.
LES ARTISTES DANS LA SÉLECTION "BIO ART"
LES OEUVRES DANS LA SÉLECTION "BIO ART"
-
Cancer Cat
€ 660,00 HT TAL DANINO
-
Little invaders n°1 (Sculpture en céramique réalisée en collaboration avec Kimi Kim)
€ 650,00 HT TAL DANINO
-
Little invaders n°10 (Sculpture en céramique réalisée en collaboration avec Kimi Kim)
€ 650,00 HT TAL DANINO
-
Little invaders n°11 (Sculpture en céramique réalisée en collaboration avec Kimi Kim)
€ 650,00 HT TAL DANINO
-
Little invaders n°2 (Sculpture en céramique réalisée en collaboration avec Kimi Kim)
€ 650,00 HT TAL DANINO
-
Little invaders n°3 (Sculpture en céramique réalisée en collaboration avec Kimi Kim)
€ 650,00 HT TAL DANINO
-
Little invaders n°4 (Sculpture en céramique réalisée en collaboration avec Kimi Kim)
€ 650,00 HT TAL DANINO
-
Little invaders n°5 (Sculpture en céramique réalisée en collaboration avec Kimi Kim)
€ 650,00 HT TAL DANINO
-
Little invaders n°6 (Sculpture en céramique réalisée en collaboration avec Kimi Kim)
€ 650,00 HT TAL DANINO
-
Little invaders n°7 (Sculpture en céramique réalisée en collaboration avec Kimi Kim)
€ 650,00 HT TAL DANINO
-
Little invaders n°8 (Sculpture en céramique réalisée en collaboration avec Kimi Kim)
€ 650,00 HT TAL DANINO
-
Little invaders n°9 (Sculpture en céramique réalisée en collaboration avec Kimi Kim)
€ 650,00 HT TAL DANINO
-
Sold Out!
Microuniverse #1
€ 210,00 HT TAL DANINO
-
MIcrouniverse Glass #1
€ 650,00–€ 5500,00 HT TAL DANINO
-
Microuniverse Glass #10
€ 650,00–€ 5500,00 HT TAL DANINO
-
Microuniverse Glass #11
€ 650,00–€ 5500,00 HT TAL DANINO
-
Microuniverse Glass #12
€ 650,00–€ 5500,00 HT TAL DANINO
-
Microuniverse Glass #13
€ 650,00–€ 5500,00 HT TAL DANINO
-
Microuniverse Glass #2
€ 650,00–€ 5500,00 HT TAL DANINO
-
Microuniverse Glass #3
€ 650,00–€ 5500,00 HT TAL DANINO
-
Microuniverse Glass #4
€ 650,00–€ 5500,00 HT TAL DANINO
-
Microuniverse Glass #5
€ 650,00–€ 5500,00 HT TAL DANINO
-
Microuniverse Glass #6
€ 650,00–€ 5500,00 HT TAL DANINO
-
Microuniverse Glass #7
€ 650,00–€ 5500,00 HT TAL DANINO
-
Microuniverse Glass #8
€ 650,00–€ 5500,00 HT TAL DANINO
-
Microuniverse Glass #9
€ 650,00–€ 5500,00 HT TAL DANINO
-
Phytoteratology N°1
€ 1500,00 HT ŠPELA PETRIČ
-
Phytoteratology N°2
€ 1500,00 HT ŠPELA PETRIČ
-
Phytoteratology N°3
€ 1500,00 HT ŠPELA PETRIČ
-
Phytoteratology N°4
€ 1500,00 HT ŠPELA PETRIČ
-
Time Displacement / Chemobrionic Garden No.1 (TD/CG No. 1)
€ 7000,00 HT Robertina Sebjanic, Ales Hieng & Ida Hirsenfelder
-
Time Displacement / Chemobrionic Garden No.2 (TD/CG No. 2)
€ 6000,00 HT Robertina Sebjanic, Ales Hieng & Ida Hirsenfelder
-
Time Displacement / Chemobrionic Garden, l’installation
€ 11500,00 HT Robertina Sebjanic, Ales Hieng & Ida Hirsenfelder